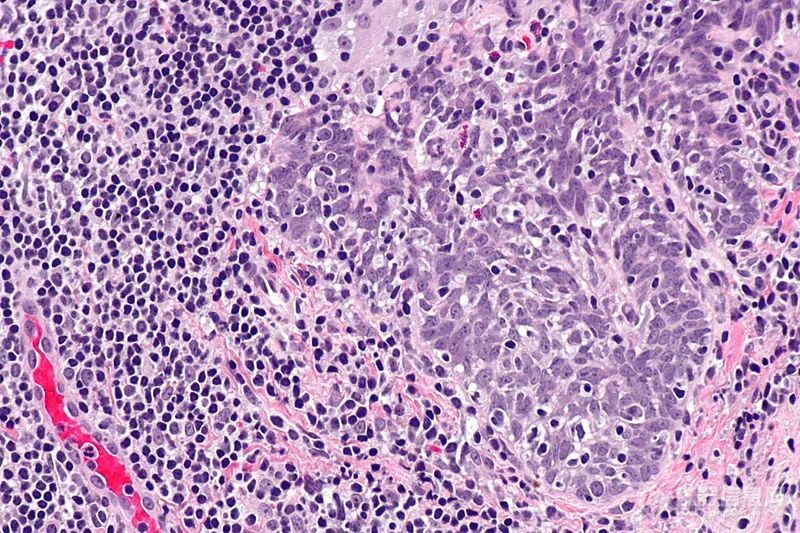
20220722-2009015706.jpg 5.jpg
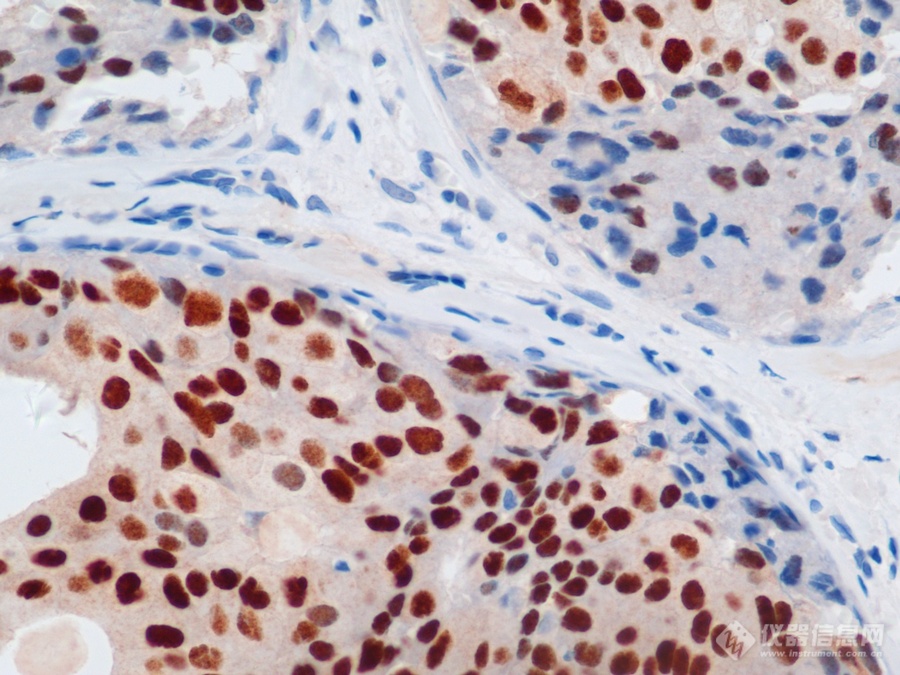
20220722-222093541.png 20220722-222093541.png

1.病毒
病毒是一种个体微小,结构简单,只含一种核酸(DNA或RNA),必须在活细胞内寄生并以复制方式增殖的非细胞型生物。病毒是一种非细胞生命形态,它由一个核酸长链和蛋白质外壳构成,病毒没有自己的代谢机构,没有酶系统。因此病毒离开了宿主细胞,就成了没有任何生命活动、也不能独立自我繁殖的化学物质。它的复制、转录和转译的能力都是在宿主细胞中进行,当它进入宿主细胞后,它就可以利用细胞中的物质和能量完成生命活动,按照它自己的核酸所包含的遗传信息产生和它一样的新一代病毒。

流感病毒渲染图
2.光学显微镜在病毒学研究中的应用
相比于常见细胞的几十微米级别尺寸,病毒的尺寸小很多,一般在60-220nm,而受制于可见光的衍射极限,光学显微镜无法分辨200nm以下的物体,因此无法对病毒进行结构尺度的观测,目前应用光学显微镜对病毒进行观测研究主要是从以下两个方面着手:(1)通过观测对病毒进行特异性标记产生的荧光信号,从而实现对病毒位置数量的判断。病毒主要由核酸和蛋白质组成,常见的一种方法是利用荧光标记的特异核酸探针与病毒含有的靶DNA分子或RNA分子进行杂交,可通过在荧光显微镜下观察荧光信号,来确定与特异探针杂交后被染色的病毒的分布和数量,这种方式也称为原位荧光杂交技术(FISH)。

FISH做的病毒检测,红色为病毒外壳蛋白
(引自公开论文https://doi.org/10.1073/pnas.1820132117)
(2)通过检测病毒入侵导致细胞产生的免疫物质或病理形态变化,从而判断病毒种类、分布和数量。正常细胞在面对病毒入侵时,会发生免疫反应,产生的免疫物质就可作为荧光染料标记的结合物,通过荧光显微镜对免疫荧光信号进行观测从而做出检测判断,这种通过对免疫蛋白进行标记的方式也称之为免疫荧光(IF),这种方式在临床上常见的应用有呼吸道七联检或九联检。

呼吸道七联检免疫荧光,MF31拍摄(绿色为病毒反应)
应用类似原理,还有不使用荧光染色的免疫组化(IHC)染色,主要用于尸检研究,判断病毒对身体各器官的感染情况,比如猴痘病毒能找到相关研究。

IHC免疫组化染色,猴痘病毒感染犬的支气管(红色为病毒反应)
病毒入侵也会导致细胞或组织发生病理变化,如感染细胞与未感染细胞的胞浆膜发生融合,形成多核的巨细胞,或某些病毒感染细胞时,在光学明场显微镜下可见胞浆或胞核内出现嗜酸或嗜碱性染色、大小不同和数量不等的圆形或不规则的团块结构,如HPV人乳头状瘤病毒。
HPV引起,分化不良的鳞状细胞癌
3.显微成像技术在病毒观测中的挑战
根据上述光学显微镜对病毒的检测方式,主要有两种方式,一是使用荧光显微镜检测荧光染料标记病毒本身的荧光信号或入侵细胞免疫反应产生抗体物质荧光信号,二是使用明场方式观测IHC或者HE染色的细胞或组织的病理形态。
主要的挑战来自病毒本身体积小,含量相对较低,导致荧光染料产生的荧光信号弱,需要使用较强的激发光与高灵敏度的显微相机进行成像;使用免疫荧光方式检测病毒对特异性染料的选择及荧光显微镜滤光片的选择要求较高,需要保证病毒标志物荧光信号不被其它种类的荧光信号所覆盖,对通道的选择及荧光图像软件的合成有很高的要求。

MF23搭配MC50-S拍摄的呼吸道病毒检测
4.明美荧光显微成像解决方案

(1)医院呼吸七联检、九联检等免疫荧光检测推荐:MF23/MF31 + 显微镜相机MC50-S/MD60/MD50-T等
长寿命LED荧光模块,即开即用,使用方便,激发效果稳定
可选单通道激发或数显多通道激发,各通道可独立连续调节
相机针对显微成像优化,可满足对实时性要求低的荧光成像

(2)宫颈癌HPV感染筛查和病毒研究等需要FISH检测的应用推荐:MF43-N+宽光谱大功率光源MG-100/MG-120+高灵敏度相机MC50-S/MS23+FISH软件
研究级机身,6孔落射荧光模块,高数值孔径物镜,成像质量高扩展性强
标配BGU三通道荧光,可按需定制单通或者双通的高质量滤光片组
长寿命LED激发光源,即开即用,触屏直观控制开关,光强可调,激发稳定
高灵敏度相机,成像帧率更高,满足更快速实时的高质量荧光成像
搭配FISH软件可实现多种荧光通道图像快速、高精度合成
(3)病毒感染的组织切片和免疫组化切片常规观测推荐:ML51-N/ML41/ML31+显微镜相机MSX2、MSX1、MDX10、MD50等
无限远平场消色差物镜,满足高质量明场观察,可扩展暗场相差等
真彩LED照明,明场状态接近自然效果,减少视觉疲劳
配备高数值孔径物镜,分辨率高,细节观测更清晰
为显微成像优化的Exmor CMOS相机,成像清晰细节丰富

(4)四大各品牌荧光显微镜升级高灵敏度显微镜相机MSX2/MC50-S/MS23
针对弱光显微成像优化,灵敏度高,成像更快速,图片更清晰
专业的适配接口搭配方案,目镜和相机可以做到视野高度同步
可选双分光接口,实现双相机实现高帧率和高分辨率兼顾

(5)四大各品牌显微镜荧光升级或LED荧光升级,数显荧光模块/荧光光源MG-100或MG-120 + 显微镜相机MC50-S等
数显荧光模块适合无限远光学显微镜升级荧光观察,高度整合,直观数显,即开即用
LED荧光光源MG-100/MG-120可取代汞灯,为荧光显微镜带来即开即用等升级体验
常规免疫荧光检测对实时性要求不高,可选MC50-S/MD60/MD50-T等显微镜相机
高实时性要求的研究级应用,可选高灵敏度相机MSX2/MC50-S/MS23和配套FISH软件
明美是一家专注显微成像产品研发与销售的高新技术企业,是中国仪器仪表行业协会光学分会理事单位,医疗器械显微镜生产及经营厂家。
公司一直坚持诚信经营,用心服务,提供显微成像解决方案。为教育、科研、医药、工业检测等广大客户提供高效、稳定的产品与服务。
始终以客户需求为中心,以品质为根本,以创新为方向,推动显微行业的数字化、电动化、智能化,为显微领域的国产化进程贡献力量。